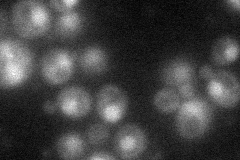
YLR119W
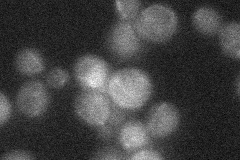
YLR119W
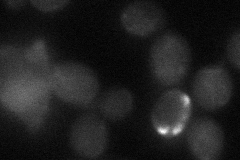
YLR119W

View description
Component of the ESCRT-I complex, which is involved in ubiquitin-dependent sorting of proteins into the endosome; suppressor of rna1-1 mutation; may be involved in RNA export from nucleus
Localization:
Intensity:
Fold change:
Significance:
-
C’ GFP library in SD

below threshold17.74 -
N' NOP1pr-GFP in SD
nucleus40.7774 -
N' TEF2pr-mCherry in SD

nucleus15.1621 -
N' NATIVEpr-GFP in SD
below threshold23.1166 -
N' TEF2pr-VC and Cyto-VN in SD
below threshold26.4054 -
C’ GFP library in SD+DTT

cytosol18.251.02No -
C’ GFP library in SD+H2O2

cytosol16.210.91No -
C’ GFP library in Starvation Media

cytosol25.821.45No -
C’ GFP library on the background of Pup2-DaMP

below threshold -
C’ GFP library on the background of CCT mutant

below threshold19.39831.09273No
